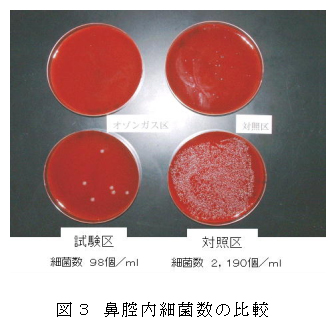

オゾンガスを利用した養豚施設の飼養衛生管理 |
||||||||
| [要約] | ||||||||
オゾン発生機と濃度計を組み合わせることにより、オゾン濃度を一定に管理する事が可能である。適正なオゾンガスで管理することにより、豚舎内の落下細菌数や鼻腔内細菌数が減少する。 |
||||||||
[キーワード]ブタ、オゾン、落下細菌数、鼻腔内細菌数、発育性 |
||||||||
[担当]神奈川畜研・畜産工学部・中小家畜グループ [連絡先]電話046-238-4056 [区分]関東東海北陸農業・畜産草地(中小家畜) [分類]技術・参考 |
||||||||
| [背景・ねらい] | ||||||||
家畜の生産性を向上させるためには、家畜の飼養環境を良好に保ち、病気の発生を予防するための定期的な消毒など畜舎環境の衛生対策が不可欠である。 |
||||||||
[成果の内容・特徴] |
||||||||
|
||||||||
[成果の活用面・留意点] |
||||||||
|
||||||||
|
||||||||
|
||||||||
[その他] |
||||||||
研究課題名:養豚施設におけるオゾン利用方法の基礎的研究 |
||||||||
| 目次へ戻る |